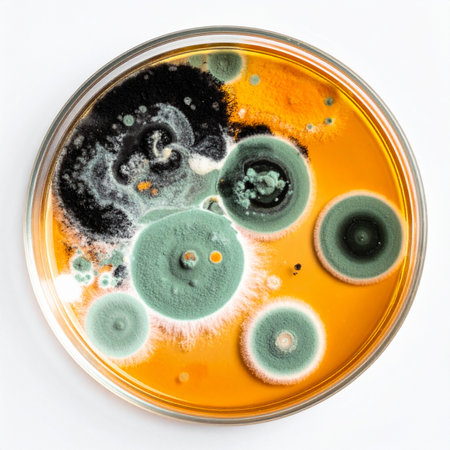
A top-down view captures a fascinating world of microbiology. In a laboratory petri dish, diverse colonies of mold and fungi flourish on an orange agar medium. This image represents scientific research, the study of microorganisms, and the potential for both contamination and groundbreaking discoveries like penicillin.の素材

素材 - A top-down view captures a fascinating world of microbiology. In a laboratory petri dish, diverse colonies of mold and fungi flourish on an orange agar medium. This image represents scientific research, the study of microorganisms, and the potential for both contamination and groundbreaking discoveries like penicillin.
作品情報
A top-down view captures a fascinating world of microbiology. In a laboratory petri dish, diverse colonies of mold and fungi flourish on an orange agar medium. This image represents scientific research, the study of microorganisms, and the potential for both contamination and groundbreaking discoveries like penicillin.
- ID:261704513
- 作品種別:
- 作者名:Yayah Mulyanti
類似作品
Aerial view of ...
An aerial view ...
aerial view of ...
Abstract night ...
A vivid aerial ...
Aerial shot of ...
Aerial shot of ...
Aerial view of ...
An aerial persp...
The city scene ...
aerial picture ...
A dynamic aeria...
Aerial view of ...
Big crack groun...
Boat in teal wa...
Experience a st...
Aerial view of ...
aerial view of ...
Beautiful view ...
Stunning aerial...
Aerial view of ...
Stunning aerial...
Stunning aerial...
Stunning aerial...
aerial view of ...
A stunning aeri...
A large circula...
Aerial photo of...
A bustling aeri...
Top view of ama...
A dynamic aeria...
Aerial overhead...
Abstract night ...
aerial view of ...
Aerial view of ...
Drone shot of a...
An aerial view ...
Aerial view of ...
bridge across w...
Winding curved ...
Aerial view of ...
Winding curved ...
Top drone view ...
An aerial view ...
Aerial view of ...
Aerial view of ...
A wide-angle sh...
Top view of a s...
A stunning aeri...